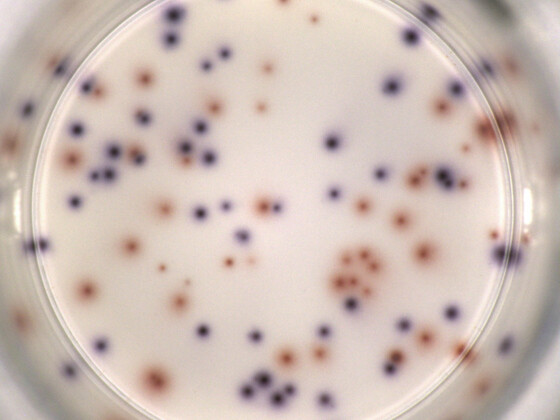

- Reader-SystemeReader-Systeme
-
EliSpot Reader Systeme
EliSpot Reader Systeme
EliSpot Reader Systeme
-
Colony Counter Reader Systeme
Colony Counter Reader Systeme
Colony Counter Reader Systeme
-
Kombi Systeme
Kombi Systeme
Kombi Systeme
-
EliSpot Reader Systeme
EliSpot Reader Systeme
- AssaysAssays
-
PCR Array Kits
PCR Array Kits
PCR Array Kits
-
PCR Genetik Kits
PCR Genetik Kits
PCR Genetik Kits
- AID Fructose Intolerance Kit
- AID Lactose Intolerance Kit
- AID Osteoporosis Kit
- AID ApoE+B Kit
- AID Heridaritary haemochromatosis Kit
- AID MTHFR Kit
- AID CVD Panel Kit
- AID Faktor V/ II + MTHFR Kit
- AID Faktor V/ II Kit
- AID BRAF Kit
- AID NRAS Kit
- AID KRAS Kit
- AID NAt2 Kit
- AID GST Kit
- AID statin tolerance Kit
- AID Cumarin panel Kit
- AID Celiac disease Kit
- AID Shared Epitope Kit
- AID HLA-b*27 Kit
-
PCR Path Kit
PCR Path Kit
PCR Path Kit
- AID FSME TBEV Kit
- AID Tick Screening Kit
- AID Periodontitis Kit
- AID MycoScreen Kit
- AID Carbapenemase Kit
- AID TB Module FQ/EMB Kit
- AID TB Module AG Kit
- AID TB Module INH/RIF Kit
- AID ESBL Kit
- AID MRSA Kit
- AID Bordetella pertussis Kit
- AID CAPvir Kit
- AID CAPbac Kit
- AID HSV 1+2 Kit
- AID Chlamydia trachomatis Kit
- AID HPV Kit
- AID STI Kit
- AID STD Kit
- FluoroSpot Basis Kit FluoroSpot Basis Kit
-
FluoroSpot Path Kits
FluoroSpot Path Kits
FluoroSpot Path Kits
- EliSpot Basis Kits EliSpot Basis Kits
- EliSpot Path Kits EliSpot Path Kits
-
B-Zell EliSpot Kits
B-Zell EliSpot Kits
B-Zell EliSpot Kits
- Antigene
-
PCR Array Kits
PCR Array Kits
- Unternehmen
- ReferenzenReferenzen